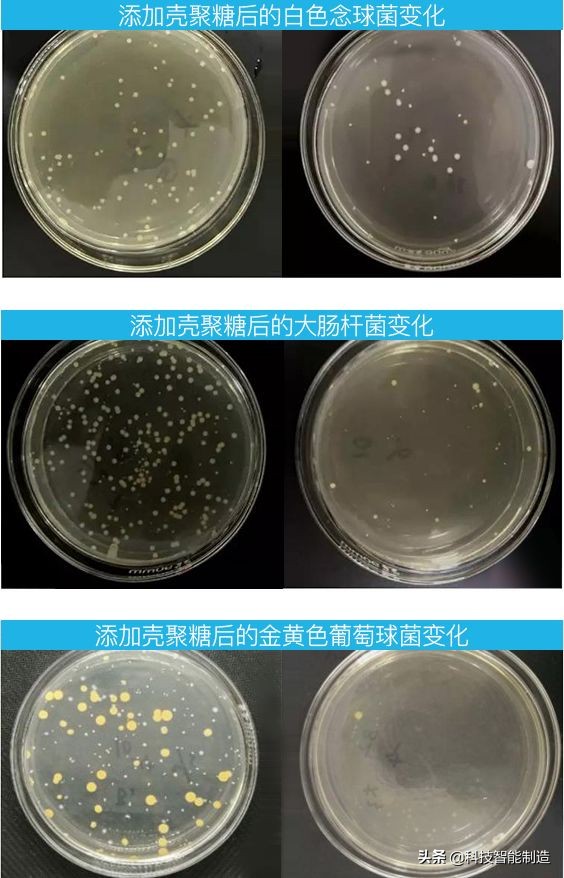
夏天防蚊黑科技,夏日防蚊黑科技

恼人的夏季蚊虫叮咬无处不在
可为了防蚊驱蚊
难道只能靠老办法吗?!

没错,可恶的蚊子又要出来猖狂了。
不但吸人的血在吸完血后你的皮肤上还会留下奇痒无比的大红包真是让人气的想骂街。
不要说爱漂亮的妹子受不了这毁容般的打击,七尺男儿也扛不住蚊子这样的追啊。
人类跟蚊子的斗争从来没有停止过,一到夏天各种战蚊神器就成了我们的宝贝

虽然知道他们有许多bug但还是咬着牙用。
蚊香不但拆的时候鸡肋,危害还那么大闻着一夜的烟味相当于在吸二手烟。
难道就没有最轻松跟蚊子作战的方法?还真有!
这次居然开发出了一款防蚊T恤,直接穿上就能防蚊子,这下简单省事多了。

科技君翻遍全网,为你找到了这件集齐8大黑科技的「全能T恤」!
历时2年研发,8次版本优化,10000人内测试穿,层层把关和筛选后,终于赶在今夏上市了!
跟市面上的运动大牌相比,价格仅有三分之一,而且一件就能实现速干、降温、防晒、驱蚊、除异味的要求。

推 荐 理 由
1.特殊超密织法,排出汗液的速度是普通面料的5倍以上,夏日不黏腻!
2.穿上体感温度立降5℃,大汗淋漓也能感到瞬间清爽,堪比“随身空调”!
3.提取天然桑蚕丝成分,面料中蕴含85%胶原蛋白,轻薄丝滑,亲肤质感!
4.抗菌除异味,让你在任何社交场合都能更自信!更体面!
5.特别添加纳米级防蚊微胶囊,蚊虫驱避率90%以上,解决夏日一大难题!
夏季蚊虫也很烦人,搞得浑身都痒也不敢挠,到了晚上蚊子一直嗡嗡叫也睡不好觉。
所以纳米级防蚊微胶囊必须安排上,蚊虫驱避率最高可达90%以上,出门连防蚊喷雾都不用喷了!

添加纳米级防蚊胶囊后,防蚊效果有了明显提升。

野外露营、爬山穿着它,蚊虫都会离你远远的。
晚上可以当睡衣穿,不用点蚊香就能驱蚊,对老人和小孩来说更健康。
85%蛋白在面料里!
天生凉感,触感丝滑,自然护肤
之所以会经过8次版本优化,就是因为品牌在对面料的选取上十分挑剔,毕竟一般的面料可驾驭不了这么多黑科技功能。

经过反复挑选,最终选取的是天生自带凉感的85%丝素蛋白纤维!


这种面料最大的特点就是比普通面料更加清凉,简直是闷热夏季的克星。
测温枪实测:普通T恤为29.4℃,而蛋白抗菌T恤为24.3℃,整整差了5℃,走在太阳底下身上也不会被晒得发烫!

左:蛋白抗菌T恤 右:普通T恤
放在胳膊上立马就有凉飕飕的感觉,而且非常顺滑,穿上身上也是舒服爆棚!
而且蛋白纤维是天然蚕丝的主要成分,对人体皮肤十分友好。

其中含有大量丝素+氨基酸活性成分,这两种成分能够增加皮肤细胞活力,促进皮肤新陈代谢,对抗皮肤敏感。
在医学应用方面,蛋白纤维对某些皮肤疾病、伤口的愈合有帮助。

如果你是易过敏体质,或者容易受到紫外线刺激,穿上它就像给皮肤穿上了一层保护膜,泛红发痒的症状会有明显的改善。

上身立降5℃!
通勤运动加倍凉爽,堪比“贴身空调”
烈日当头,满身大汗的时候,穿上这件T恤还会有被“瞬间降温”的感觉,尤其是运动后效果更明显。
炎热的夏季穿上它就像穿了一台“制冷空调”,健身房撸铁2小时也不会闷热。

再加上冰凉的面料触感,上身体感温度会骤降5℃,就像被冰水浇过一样,整个人从头爽到脚!
日常通勤、运动、晚上遛弯都能穿,穿上它,无论走到哪都自带了一台小空调~

自带10000个散热孔!
清爽透气,一甩即干,告别闷汗
如果衣服的透气性太差,就会越捂越热,就跟身上糊了一层塑料布似的。

这件「全能T恤」是怎么保证良好透气性的呢?
2年研发不是白来的,这款T恤采用特殊的超密织法,全身自带10000个透气孔,气孔间的沟槽产生虹吸作用,可以迅速吸收汗液,扩散,蒸发。

即使你走在街上汗如雨下,T恤也不会黏在身上,一阵风吹过汗水和暑气都消散了~


而普通的棉质T恤就经不住这种考验,夏天刚出一点汗基本就是这种效果了↓
让人看着都难受...

经过测试,跟传统的纯棉面料相比,这款T恤的透气性强50%,是你想象不到的那种清爽透气感。
隔着衣服也丝毫不会影响加湿器的水汽透过,穿一天也不会黏黏乎乎。


抑菌率高达97%
摆脱异味尴尬,防晒驱蚊虫
夏季的汗水变成了细菌繁殖的温床,即使是没有体味的人也难免会有酸臭的汗味。

所以要想摆脱异味,抑菌是关键!
所以这件T恤在面料中添加了从深海海藻中提取的壳聚糖,壳聚糖具有很强的抗菌防臭性,对32种真菌都能起到抑制作用。

通过对比添加了壳聚糖的衣服,和未添加壳聚糖的衣服,可以明显的看到,添加了壳聚糖的衣服中,细菌会逐渐失去活性,自然脱落。
抑菌效果显而易见!
经国家权威机构检测,对大肠杆菌的抑菌率最高可达97%。
如果纯棉、化纤的衣服会经常让你的皮肤瘙痒、长痘、湿疹...换上这件T恤说不定会舒服很多。

暴晒10分钟,皮肤就好像老了10岁,就算男生不在意长皱纹,晒黑了也不好看啊。
但很多男生觉得打防晒伞不够酷,那就赶紧穿上这件T恤吧。

经过测试,这款T恤抗紫外线强度达到了UPF40+,基本和黑胶伞的防晒程度差不多,户外运动也没有问题。
而普通的棉质面料仅仅能达到UPF10-20,如果长时间暴露在户外还是穿这件T恤更靠谱。

通过采用专业紫外线测试仪测试,穿上这款蛋白T恤后的紫外线指数直降30倍!

这个防晒能力,防紫外线能力真的很靠谱!


这么好的全能T恤:速干、降温、防晒、能除异味还能驱蚊,这个夏天你一定想拥有一件吧。
点击下方的横幅购买只需要128元哦~
量橙蛋白kang菌速干T恤 集八大黑科技于一身的功能T恤
¥128
购买